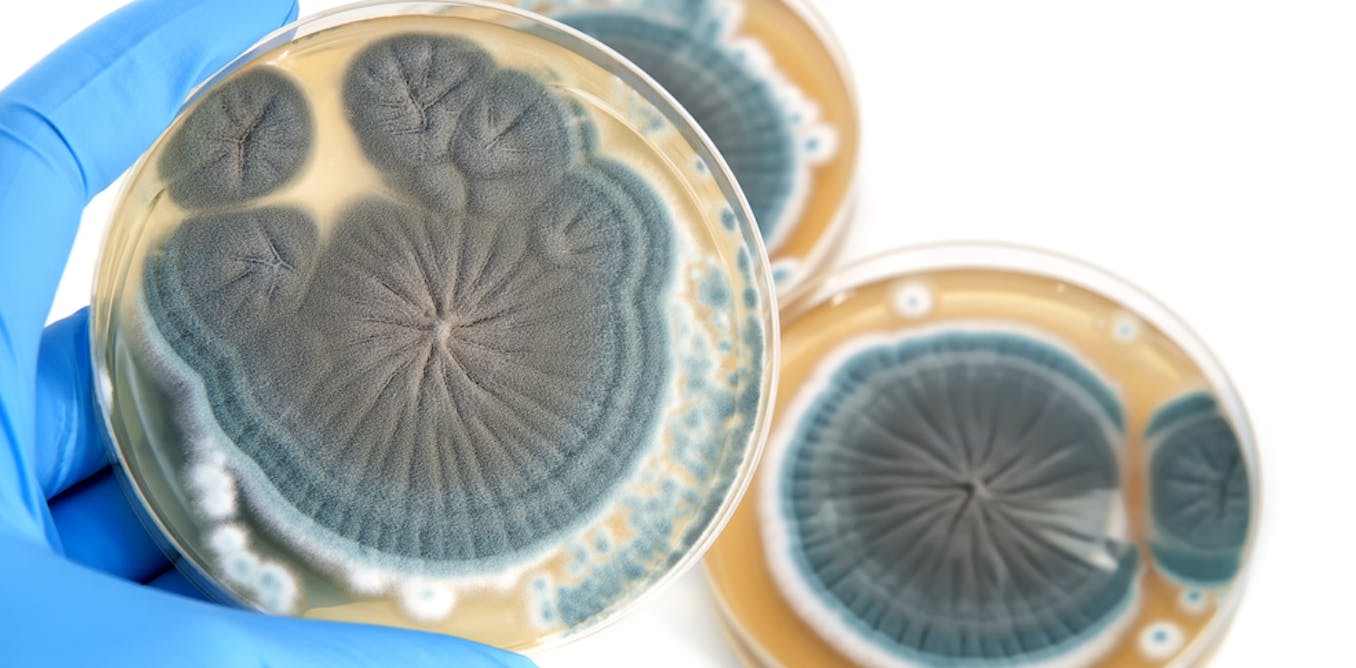

Penicillin is a group of antibiotics that are derived from the Penicillium fungi. Here's a comprehensive overview:
History:
- Discovery: Penicillin was discovered by Alexander Fleming in 1928. He observed that a mold (Penicillium notatum) inhibited bacterial growth.
 |
| ALEXANDER FLEMMING |
 |
| PENICILLIN |
- Development: During World War II, mass production techniques were developed, making penicillin widely available and saving countless lives.
PENICILLIN FULL EXPLANATION VIDEO:
Mechanism of Action:
- Function: Penicillin works by interfering with bacterial cell wall synthesis. It inhibits the enzyme transpeptidase, which is essential for the cross-linking of peptidoglycan layers in bacterial cell walls.
- Result: This leads to cell lysis and death, particularly effective against Gram-positive bacteria.
Types of Penicillin
Natural Penicillins:
- Penicillin G: Effective against many Gram-positive bacteria and some Gram-negative bacteria. Administered intravenously or intramuscularly.
- Penicillin V: Similar to Penicillin G but more stable in acidic environments, allowing oral administration.
Aminopenicillins:
- Amoxicillin: Broad-spectrum antibiotic effective against a wider range of bacteria compared to natural penicillins. Commonly used for respiratory infections, ear infections, and more.
- Ampicillin: Similar to amoxicillin but less frequently used.
Penicillinase-Resistant Penicillins:
- Methicillin: Designed to resist inactivation by staphylococcal penicillinase (an enzyme that destroys penicillin).
- Oxacillin and Cloxacillin: Alternatives to methicillin, used for treating staphylococcal infections.
Extended-Spectrum Penicillins:
- Piperacillin: Effective against a broader range of bacteria, including some Gram-negative bacteria. Often combined with a beta-lactamase inhibitor like tazobactam.
Pharmacokinetics :
Absorption:
The potassium salt of penicillin V (oral formulation) is resistant to inactivation by gastric acid; however, penicillin G is destroyed by stomach acid. Benzathine penicillin G has slow hydrolysis and absorption, resulting in a prolonged half-life.
Distribution:
Penicillin V and penicillin G have approximately 80% and 60% plasma protein binding, respectively. Tissue levels are highest in the kidneys. The concentration of penicillin in abscesses, synovial, and peritoneal fluids is higher in the presence of inflammation. However, penicillin G does have poor distribution in polymorphonuclear leukocytes.
Metabolism:
Penicillin derivatives are minimally metabolized by the liver. Organic anion transporter-3 plays a vital role in renal excretion
Elimination:
These agents are rapidly excreted in the urine as they are water-soluble, and others are excreted in bile. Penicillin has a relatively short half-life of about 2 hours. Penicillin is excreted rapidly by tubular excretion, which is inhibited by probenecid.
Uses :
- Infections: Treats infections caused by susceptible bacteria, including strep throat, syphilis, and certain skin infections.
- Prophylaxis: Sometimes used to prevent infections before surgical procedures or in high-risk individuals.
Side Effects
- Common: Nausea, vomiting, diarrhea, and allergic reactions.
- Severe: Anaphylaxis (a severe allergic reaction), Clostridium difficile infection (leading to severe diarrhea), and resistance.
Allergic Reactions
- Prevalence: Allergies to penicillin are relatively common. Symptoms range from mild rashes to severe anaphylaxis.
- Management: Individuals with known allergies should avoid penicillin and its derivatives. Alternative antibiotics may be prescribed.
Resistance
- Mechanisms: Bacteria can develop resistance through various mechanisms, such as producing beta-lactamases that break down penicillin.
- Combating Resistance: Combination therapies with beta-lactamase inhibitors (e.g., clavulanic acid) can help overcome some resistance issues.
Administration
Available Dosage Forms, Strengths, and Dosages
Penicillin G can be administrated by intravenous (IV) or intramuscular (IM) route. Penicillin G potassium for injection USP vial is available in 1 million units, 5 million units, and 20 million units per vial. Because of the short half-life, penicillin G is usually administered in divided doses 4 to 6 hours apart via the IV or IM route. Penicillin G benzathine administration ensures a continuous low dose of penicillin G over 2 to 4 weeks. FDA has also approved a procaine penicillin G combination of antibiotics and local anesthetics.
Penicillin V and its potassium salt derivative, penicillin VK, are accessible in orally administered forms, including solutions for reconstitution (125 mg/5 mL and 250 mg/5 mL) and tablets (250 mg and 500 mg). Penicillin V is best administered to a fasting patient as it degrades in stomach acid. Based on the clinical indication and patient weight, the usual dosage ranges from 125 to 500 mg every 6 to 8 hours.
As with any antibiotic, patients should be advised to finish the treatment course to prevent bacterial resistance. Penicillin demonstrates limited crossing of the blood-brain barrier. According to the Infectious Diseases Society of America (IDSA), penicillin G is recommended for bacterial meningitis caused by susceptible organisms such as Propionibacterium acnes. According to the Centers for Disease Control and Prevention (CDC), penicillin should not be used as first-line therapy for treatment or post exposure prophylaxis for anthrax until susceptibility results.
Specific Patient Populations
Hepatic impairment:
- Hepatic impairment warrants caution, particularly in cirrhosis cases, due to hypoalbuminemia.
Renal impairment:
- Although renal impairment is not a contraindication for penicillin, doses must be adjusted given end-stage renal disease.
- Depending on the glomerular filtration rate, these patients will receive a full loading dose and half a loading dose every 8 to 10 or 4 to 5 hours.
Pregnancy considerations:
- Penicillin G belongs to the FDA pregnancy category B drug. No severe adverse events are observed with penicillin G.
- Eliminating penicillin V is increased during pregnancy, requiring dose adjustment with an increased dose of the standard dosing interval or shorter dosing intervals of the standard dose.
- According to the American College of Obstetricians and Gynecologists (ACOG) guidelines, penicillin G is recommended for group B Streptococcus (GBS) prophylaxis.
- The recommendation is a loading dose of 5 million units followed by 2.5 to 3 million units every 4 hours till delivery.
Breastfeeding considerations:
- According to the literature, penicillin G and penicillin V are found in milk at low levels that are unexpected to cause adverse reactions in breastfed infants. Some research has reported that penicillin can disrupt the infant's gastrointestinal flora, causing diarrhea or thrush; however, these adverse effects have not been adequately evaluated. The use of penicillin G or penicillin V is acceptable for nursing mothers.
Paediatric patients: The pediatric dose of penicillin is calculated based on the body surface area and weight. The CDC recommends Benzathine penicillin G 50,000 units/kg IM, up to 2.4 million units in a single dose for treating primary and secondary syphilis.
Older patients: Older patients should exercise caution when using due to the potential for reduced glomerular filtration rate.
Adverse Effects :
Penicillin V and G can have adverse effects, including
- Nausea,
- Vomiting,
- Diarrhea,
- Rash,
- Abdominal pain,
- Urticaria.
In addition, Penicillin G can have other adverse reactions, including - Muscle spasms,
- Fever,
- Chills,
- Muscle pain,
- Headache,
- Tachycardia,
- Flushing,
- Tachypnea, and
- Hypotension.
Hypersensitivity reactions: The commonly encountered adverse drug reaction with penicillin is hypersensitivity of immediate onset or delayed onset.
Immediate onset: This type of reaction occurs within 20 minutes after administering the drug and is characterized by urticaria, pruritis, edema, laryngospasm, bronchospasm, hypotension, vascular collapse, and death.
Delayed onset: This type of reaction occurs within 1 to 2 weeks of treatment, is rare, and is characterized by fever, malaise, urticaria, myalgia, arthralgia, abdominal pain, and skin rashes.
Gastrointestinal system: Gastrointestinal symptoms, including nausea, vomiting, and stomatitis, were the most commonly reported in over 1% of patients and widely observed with oral administration. Pseudomembranous colitis is also observed during or after the treatment.
Hematologic reactions: If the dose exceeds 10 million units per day and a patient has received a higher dose previously, then those patients can precipitate Coombs-positive hemolytic anemia and neutropenia, resolved when therapy is stopped.
Metabolic reactions: The salt form of penicillin G may cause electrolyte imbalances, such as hyperkalemia, when given IV in a large dose.
Nervous system: Neurological manifestations include hyperreflexia, myoclonic cramps, seizures, and coma after IV doses and are more likely in patients with impaired renal function.
Urogenital system: Urological manifestations with large IV doses include renal tubular damage. Penicillins can also cause acute interstitial nephritis, a disease characterized by inflammation of the tubules and interstitium of the kidneys. Acute interstitial nephritis can also present with hematuria, fever, and rash. The recommendation is to withdraw the drug as the disease could lead to renal failure.
Other reactions: Jarisch- Herxheimer reaction is precipitated when penicillin is administered in patients with syphilis due to rapid lysis of spirochetes and release of endotoxins. Procaine reactions (1 in 500 patients) are due to immediate toxic reactions to procaine due to large single-dose administration. Procaine may cause a pseudoanaphylactic reaction. Procaine can also cause methemoglobinemia.
Drug-Drug Interactions
Concurrent sulfonamides, erythromycin, and chloramphenicol (bacteriostatic drugs) should be avoided due to antagonistic effects.
Tubular secretion of penicillin G is blocked by probenecid- higher and longer plasma concentrations are achieved. Probenecid also decreases the volume of distribution of penicillin.
Drugs such as aspirin, phenylbutazone, sulfonamides, indomethacin, thiazide, furosemide, and ethacrynic acid increase the half-life of penicillin by competing with tubular secretion.
Contraindications
Contraindications of penicillin include a previous history of severe allergic reactions to penicillin or its derivatives. Penicillin is also contraindicated in patients with a prior history of Stevens-Johnson syndrome after administering penicillin or a penicillin derivative. In addition, penicillin has an antagonistic effect with tetracyclines and can lead to a 2.6 times higher mortality risk when treating pneumococcal meningitis than penicillin alone. However, Penicillins are relatively safe to use during pregnancy and lactation.
Nearly all antibacterial agents have been linked to Clostridium difficile–associated diarrhea (CDAD), including penicillin, with severity ranging from mild diarrhea to fatal colitis. Antibacterial agents alter the colon's normal flora, causing the overgrowth of C difficile. This strain produces toxins A and B that contribute to the development of CDAD. During infections caused by hypertoxin-producing strains of C difficile, the morbidity and mortality rate is increased since these infections are often resistant to antimicrobial treatments and may require colectomy. Antibiotic treatment is recommended when CDAD is suspected or confirmed. Depending on clinical need, protein supplementation, fluid and electrolyte management, antibiotic treatment, and surgical evaluation are implemented.
Monitoring
Generally, the monitoring of patients on penicillin is not required. However, one study recommended therapeutic drug monitoring during endocarditis treatment caused by enterococci to determine penicillin exposure and dosing. This vigilance will decrease the chance of antibiotic resistance while improving therapeutic impact. Prolonged administration of penicillin requires monitoring hematologic, renal, and hepatic function.
Toxicity
Signs and Symptoms of Overdose
Penicillin has a small risk of toxicity. Clinicians can administer penicillin at relatively high doses compared to other drugs without harming patients. Estimates are that it would take 5 g/kg body weight IV to cause convulsions in a patient. However, penicillin can cause local toxicity due to high-dose injections at sensitive sites such as the eye's anterior chamber or the subarachnoid space. Reports show that pure preparations of penicillin cause no harm to the lungs and veins. Other reports indicate that topical penicillin can prevent coagulation in dental cavities.
Management of Overdose
Neurotoxicity of penicillin requires discontinuation of the offending penicillin. Penicillin are hypothesized to have an inhibitory effect on GABA transmission; consequently, IV benzodiazepines and electroencephalogram (EEG) monitoring may be necessary in refractory cases.
Enhancing Healthcare Team Outcomes
Before prescribing penicillin to a patient, the prescribing clinician and consulting team should confirm that the underlying infection is likely the result of bacteria sensitive to penicillin. The prescriber, pharmacist, and nurse should also counsel the patient on any adverse drug effects that should prompt a return visit, such as prolonged diarrhea or severe rash. Clinicians should notify the CDC if the zoonotic disease is suspected, and infectious disease consultation should be obtained. In an outpatient setting, communication between the clinician and the pharmacist will allow the drug to be dispensed appropriately to the patient.
Pharmacists should consult the patient on how best to administer the penicillin and remind them that they should complete the entire course of the antibiotic. This interprofessional approach will optimize therapeutic results while minimizing adverse effects. A retrospective study concluded that a team approach between infectious disease pharmacists with advanced pharmacy practice experience improves antimicrobial stewardship interventions.
If a patient has difficulty obtaining drugs for financial or logistical reasons, a social worker may help ensure that the patient receives their medications. In an inpatient setting, communication between the clinician and the nurse will allow the patient to receive the drug. The healthcare team can work together to confirm that the patient has no contraindications to penicillin use.
If any immediate severe adverse effects occur after administering penicillin, such as anaphylaxis, the healthcare team should receive notification and treat the acute condition immediately. A board-certified infectious disease pharmacist can also consult on the case to confirm if penicillin is the best choice given the patient's diagnosis, current antibiogram data, and any other medications the patient is prescribed. Furthermore, a flattened hierarchy approach should be in place to ensure that reporting mistakes to a superior can take place without resistance. Utilizing the entire healthcare team is critical to ensure the patient is comfortable and has the best medical outcome with the lowest chance of complications. Interprofessional coordination and collaboration among physicians, nurse practitioners, physician assistants, pharmacists, and nurses can improve patient outcomes while using penicillin for treating susceptible infections.
References :
- 1.
Friedland IR, McCracken GH. Management of infections caused by antibiotic-resistant Streptococcus pneumoniae. N Engl J Med. 1994 Aug 11;331(6):377-82. [PubMed] - 2.
Herman DJ, Gerding DN. Antimicrobial resistance among enterococci. Antimicrob Agents Chemother. 1991 Jan;35(1):1-4. [PMC free article] [PubMed] - 3.
Spratt BG, Cromie KD. Penicillin-binding proteins of gram-negative bacteria. Rev Infect Dis. 1988 Jul-Aug;10(4):699-711. [PubMed] - 4.
Perry CM, Markham A. Piperacillin/tazobactam: an updated review of its use in the treatment of bacterial infections. Drugs. 1999 May;57(5):805-43. [PubMed] - 5.
Kache PA, Person MK, Seeman SM, McQuiston JR, McCollum J, Traxler RM. Rat-Bite Fever in the United States: An Analysis Using Multiple National Data Sources, 2001-2015. Open Forum Infect Dis. 2020 Jun;7(6):ofaa197. [PMC free article] [PubMed] - 6.
Harcourt BH, Anderson RD, Wu HM, Cohn AC, MacNeil JR, Taylor TH, Wang X, Clark TA, Messonnier NE, Mayer LW. Population-Based Surveillance of Neisseria meningitidis Antimicrobial Resistance in the United States. Open Forum Infect Dis. 2015 Sep;2(3):ofv117. [PMC free article] [PubMed] - 7.
Dunaway SB, Maxwell CL, Tantalo LC, Sahi SK, Marra CM. Neurosyphilis Treatment Outcomes After Intravenous Penicillin G Versus Intramuscular Procaine Penicillin Plus Oral Probenecid. Clin Infect Dis. 2020 Jul 11;71(2):267-273. [PMC free article] [PubMed] - 8.
Gillam DG, Turner W. Antibiotics in the treatment of periodontal disease: a guide for the general dental practitioner. Prim Dent J. 2014 Aug;3(3):43-7. [PubMed] - 9.
Wyber R, Taubert K, Marko S, Kaplan EL. Benzathine Penicillin G for the Management of RHD: Concerns About Quality and Access, and Opportunities for Intervention and Improvement. Glob Heart. 2013 Sep;8(3):227-34. [PubMed] - 10.
Workowski KA, Bolan GA., Centers for Disease Control and Prevention. Sexually transmitted diseases treatment guidelines, 2015. MMWR Recomm Rep. 2015 Jun 05;64(RR-03):1-137. [PMC free article] [PubMed] - 11.
Fisher JF, Mobashery S. Constructing and deconstructing the bacterial cell wall. Protein Sci. 2020 Mar;29(3):629-646. [PMC free article] [PubMed] - 12.
Gordon E, Mouz N, Duée E, Dideberg O. The crystal structure of the penicillin-binding protein 2x from Streptococcus pneumoniae and its acyl-enzyme form: implication in drug resistance. J Mol Biol. 2000 Jun 02;299(2):477-85. [PubMed] - 13.
Espinosa-Gongora C, Jessen LR, Kieler IN, Damborg P, Bjørnvad CR, Gudeta DD, Pires Dos Santos T, Sablier-Gallis F, Sayah-Jeanne S, Corbel T, Nevière A, Hugon P, Saint-Lu N, de Gunzburg J, Guardabassi L. Impact of oral amoxicillin and amoxicillin/clavulanic acid treatment on bacterial diversity and β-lactam resistance in the canine faecal microbiota. J Antimicrob Chemother. 2020 Feb 01;75(2):351-361. [PubMed] - 14.
Wolman AT, Gionfriddo MR, Heindel GA, Mukhija P, Witkowski S, Bommareddy A, Vanwert AL. Organic anion transporter 3 interacts selectively with lipophilic β-lactam antibiotics. Drug Metab Dispos. 2013 Apr;41(4):791-800. [PubMed] - 15.
Barker CI, Germovsek E, Sharland M. What do I need to know about penicillin antibiotics? Arch Dis Child Educ Pract Ed. 2017 Feb;102(1):44-50. [PubMed] - 16.
Wilson RC, Arkell P, Riezk A, Gilchrist M, Wheeler G, Hope W, Holmes AH, Rawson TM. Addition of probenecid to oral β-lactam antibiotics: a systematic review and meta-analysis. J Antimicrob Chemother. 2022 Aug 25;77(9):2364-2372. [PMC free article] [PubMed] - 17.
Robbins N, Gilbert M, Kumar M, McNamara JW, Daly P, Koch SE, Conway G, Effat M, Woo JG, Sadayappan S, Rubinstein J. Probenecid Improves Cardiac Function in Patients With Heart Failure With Reduced Ejection Fraction In Vivo and Cardiomyocyte Calcium Sensitivity In Vitro. J Am Heart Assoc. 2018 Jan 13;7(2) [PMC free article] [PubMed] - 18.
LiverTox: Clinical and Research Information on Drug-Induced Liver Injury [Internet]. National Institute of Diabetes and Digestive and Kidney Diseases; Bethesda (MD): Oct 20, 2020. Penicillins (1st Generation) [PubMed] - 19.
Tunkel AR, Hasbun R, Bhimraj A, Byers K, Kaplan SL, Scheld WM, van de Beek D, Bleck TP, Garton HJL, Zunt JR. 2017 Infectious Diseases Society of America's Clinical Practice Guidelines for Healthcare-Associated Ventriculitis and Meningitis. Clin Infect Dis. 2017 Mar 15;64(6):e34-e65. [PMC free article] [PubMed] - 20.
Parker CM, Karchmer AW, Fisher MC, Muhammad KM, Yu PA. Safety of Antimicrobials for Postexposure Prophylaxis and Treatment of Anthrax: A Review. Clin Infect Dis. 2022 Oct 17;75(Suppl 3):S417-S431. [PMC free article] [PubMed] - 21.
Zoratti C, Moretti R, Rebuzzi L, Albergati IV, Di Somma A, Decorti G, Di Bella S, Crocè LS, Giuffrè M. Antibiotics and Liver Cirrhosis: What the Physicians Need to Know. Antibiotics (Basel). 2021 Dec 28;11(1) [PMC free article] [PubMed] - 22.
Smyth B, Jones C, Saunders J. Prescribing for patients on dialysis. Aust Prescr. 2016 Feb;39(1):21-4. [PMC free article] [PubMed] - 23.
Heikkilä AM, Erkkola RU. The need for adjustment of dosage regimen of penicillin V during pregnancy. Obstet Gynecol. 1993 Jun;81(6):919-21. [PubMed] - 24.
Prevention of Group B Streptococcal Early-Onset Disease in Newborns: ACOG Committee Opinion, Number 797. Obstet Gynecol. 2020 Feb;135(2):e51-e72. [PubMed] - 25.
Drugs and Lactation Database (LactMed®) [Internet]. National Institute of Child Health and Human Development; Bethesda (MD): Feb 15, 2021. Penicillin V. [PubMed] - 26.
Drugs and Lactation Database (LactMed®) [Internet]. National Institute of Child Health and Human Development; Bethesda (MD): Feb 15, 2021. Penicillin G. [PubMed] - 27.
Abdulkader RCRM, Burdmann EA, Lebrão ML, Duarte YAO, Zanetta DMT. Aging and decreased glomerular filtration rate: An elderly population-based study. PLoS One. 2017;12(12):e0189935. [PMC free article] [PubMed] - 28.
Bhattacharya S. The facts about penicillin allergy: a review. J Adv Pharm Technol Res. 2010 Jan;1(1):11-7. [PMC free article] [PubMed] - 29.
Chow KM, Hui AC, Szeto CC. Neurotoxicity induced by beta-lactam antibiotics: from bench to bedside. Eur J Clin Microbiol Infect Dis. 2005 Oct;24(10):649-53. [PubMed] - 30.
Finnigan NA, Rout P, Leslie SW, Bashir K. StatPearls [Internet]. StatPearls Publishing; Treasure Island (FL): Sep 12, 2023. Allergic and Drug-Induced Interstitial Nephritis. [PubMed] - 31.
Belum GR, Belum VR, Chaitanya Arudra SK, Reddy BS. The Jarisch-Herxheimer reaction: revisited. Travel Med Infect Dis. 2013 Jul-Aug;11(4):231-7. [PubMed] - 32.
Gaig P, Paniagua MJ. [Hoigne's syndrome]. Allergol Immunopathol (Madr). 2005 Jan-Feb;33(1):57-8. [PubMed] - 33.
McNulty R, Kuchi N, Xu E, Gunja N. Food-induced methemoglobinemia: A systematic review. J Food Sci. 2022 Apr;87(4):1423-1448. [PubMed] - 34.
Ocampo PS, Lázár V, Papp B, Arnoldini M, Abel zur Wiesch P, Busa-Fekete R, Fekete G, Pál C, Ackermann M, Bonhoeffer S. Antagonism between bacteriostatic and bactericidal antibiotics is prevalent. Antimicrob Agents Chemother. 2014 Aug;58(8):4573-82. [PMC free article] [PubMed] - 35.
Ivanyuk A, Livio F, Biollaz J, Buclin T. Renal Drug Transporters and Drug Interactions. Clin Pharmacokinet. 2017 Aug;56(8):825-892. [PubMed] - 36.
Levison ME, Levison JH. Pharmacokinetics and pharmacodynamics of antibacterial agents. Infect Dis Clin North Am. 2009 Dec;23(4):791-815, vii. [PMC free article] [PubMed] - 37.
Smits WK, Lyras D, Lacy DB, Wilcox MH, Kuijper EJ. Clostridium difficile infection. Nat Rev Dis Primers. 2016 Apr 07;2:16020. [PMC free article] [PubMed] - 38.
Öbrink-Hansen K, Wiggers H, Bibby BM, Hardlei TF, Jensen K, Kragh Thomsen M, Brock B, Petersen E. Penicillin G Treatment in Infective Endocarditis Patients - Does Standard Dosing Result in Therapeutic Plasma Concentrations? Basic Clin Pharmacol Toxicol. 2017 Feb;120(2):179-186. [PubMed] - 39.
STEWART GT. TOXICITY OF THE PENICILLINS. Postgrad Med J. 1964 Dec;40(Suppl):SUPPL:160-9. [PMC free article] [PubMed] - 40.
Grill MF, Maganti RK. Neurotoxic effects associated with antibiotic use: management considerations. Br J Clin Pharmacol. 2011 Sep;72(3):381-93. [PMC free article] [PubMed] - 41.
Cusumano JA, Defrank A, Funk OG, Lerner P, Tanprayoon M, Vasa C, Mazo D. The Role of an Infectious Diseases Faculty Pharmacist and Pharmacy Students on an Antimicrobial Stewardship Team at a Community Non-teaching Hospital. J Pharm Pract. 2024 Apr;37(2):335-342. [PubMed]
Copyright © 2024, StatPearls Publishing LLC.This book is distributed under the terms of the Creative Commons Attribution-NonCommercial-NoDerivatives 4.0 International (CC BY-NC-ND 4.0) ( http://creativecommons.org/licenses/by-nc-nd/4.0/ ), which permits others to distribute the work, provided that the article is not altered or used commercially. You are not required to obtain permission to distribute this article, provided that you credit the author and journal.